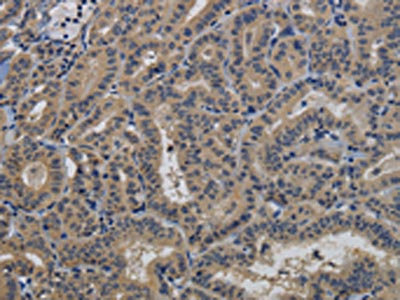

TAB1 Antibody
-
中文名稱:TAB1兔多克隆抗體
-
貨號:CSB-PA958657
-
規(guī)格:¥1100
-
圖片:
-
The image on the left is immunohistochemistry of paraffin-embedded Human liver cancer tissue using CSB-PA958657(TAB1 Antibody) at dilution 1/40, on the right is treated with fusion protein. (Original magnification: ×200)
-
The image on the left is immunohistochemistry of paraffin-embedded Human thyroid cancer tissue using CSB-PA958657(TAB1 Antibody) at dilution 1/40, on the right is treated with fusion protein. (Original magnification: ×200)
-
-
其他:
產(chǎn)品詳情
-
Uniprot No.:
-
基因名:
-
別名:2310012M03Rik antibody; 3'-Tab1 antibody; MAP3K7IP 1 antibody; MAP3K7IP1 antibody; MGC57664 antibody; Mitogen activated protein kinase kinase kinase 7 interacting protein 1 antibody; Mitogen-activated protein kinase kinase kinase 7-interacting protein 1 antibody; TAB 1 antibody; TAB1 antibody; TAB1_HUMAN antibody; TAK1 binding protein 1 antibody; TAK1-binding protein 1 antibody; TGF beta activated kinase 1 binding protein 1 antibody; TGF-beta activated kinase 1/MAP3K7 binding protein 1 antibody; TGF-beta-activated kinase 1 and MAP3K7-binding protein 1 antibody; TGF-beta-activated kinase 1-binding protein 1 antibody; Transforming growth factor beta activated kinase binding protein 1 antibody
-
宿主:Rabbit
-
反應種屬:Human,Mouse
-
免疫原:Fusion protein of Human TAB1
-
免疫原種屬:Homo sapiens (Human)
-
標記方式:Non-conjugated
-
抗體亞型:IgG
-
純化方式:Antigen affinity purification
-
濃度:It differs from different batches. Please contact us to confirm it.
-
保存緩沖液:-20°C, pH7.4 PBS, 0.05% NaN3, 40% Glycerol
-
產(chǎn)品提供形式:Liquid
-
應用范圍:ELISA,IHC
-
推薦稀釋比:
Application Recommended Dilution ELISA 1:2000-1:5000 IHC 1:50-1:200 -
Protocols:
-
儲存條件:Upon receipt, store at -20°C or -80°C. Avoid repeated freeze.
-
貨期:Basically, we can dispatch the products out in 1-3 working days after receiving your orders. Delivery time maybe differs from different purchasing way or location, please kindly consult your local distributors for specific delivery time.
-
用途:For Research Use Only. Not for use in diagnostic or therapeutic procedures.
相關產(chǎn)品
靶點詳情
-
功能:May be an important signaling intermediate between TGFB receptors and MAP3K7/TAK1. May play an important role in mammalian embryogenesis.
-
基因功能參考文獻:
- High TAB1 expression is associated with colorectal cancer. PMID: 29328486
- TAB1 was identified as a functional target of miR-134, and the expression of TAB1 was increased by the transcription factors of NF-kappaB1, c-Rel, and ELK1 via miR-134. PMID: 28206956
- we show that IL-1 induces robust p38a activation both in the nucleus and in the cytoplasm/membrane.Following stimulation, p38a activity returns to a basal level in absence of receptor degradation. While nuclear pulse is controlled by MKP1 through a negative feedback to pp38, its basal activity is controlled by both TAB1 and MKP1 through a positive feedback loop. PMID: 27314954
- TAK1/TAB1 expression in non-small cell lung carcinoma tissue is significantly increased and closely associated with patient clinical prognosis. PMID: 26884850
- miR-29a repressed TAB1-mediated TIMP-1 production in dermal fibroblasts, demonstrating that miR-29a may be a therapeutic target in SSc. PMID: 25549087
- Data indicate that mitogen-activated protein kinase (MAPK) p38 activation is triggered by AMP-activated protein kinases (AMPK) and mediated by TAB1 protein. PMID: 25151490
- The amino acid sequence between positions 373 and 502 of TAB1 is required for TP interaction. PMID: 24462677
- USP18 inhibits NF-kappaB and NFAT activation during Th17 differentiation by deubiquitinating the TAK1-TAB1 complex. PMID: 23825189
- We found that endothelial TAK1 and TAB2, but not TAB1, were critically involved in vascular formation PMID: 22972987
- TAK1 plays a critical role in accentuated epithelial to mesenchymal transition in obliterative bronchiolitis after lung transplantation. PMID: 22525462
- data suggest a complex role of aa 452-457 of TAB1 in controlling p38 MAPK activity and subcellular localization and implicate these residues in TAK1- or p38 MAPK-dependent post-transcriptional control of gene expression PMID: 22216226
- Phosphorylation and polyubiquitination of TAK1 are necessary for activation of NF-kappaB by the Kaposi's sarcoma-associated herpesvirus vGPCR. PMID: 21159881
- Observational study of gene-disease association, gene-gene interaction, gene-environment interaction, and pharmacogenomic / toxicogenomic. (HuGE Navigator) PMID: 20805296
- Co-expression of TAK1 and TAB1 resulted in a functional and active TAK1-TAB1 complex capable of directly activating full-length heterotrimeric mammalian AMP-activated protein kinase (AMPK) in vitro. PMID: 20538596
- interaction with p38alpha leads to autophosphorylation and activation of p38alpha PMID: 11847341
- The TAK1-TAB1 fusion protein is a novel constitutively active mitogen-activated protein kinase kinase kinase that stimulates AP-1 and NF-kappaB signaling pathways PMID: 12372426
- TauAlphaBeta1beta is involved in regulating p38alpha activity in physiological conditions PMID: 12429732
- These results suggest that the TAK1-NLK MAPK cascade is activated by the noncanonical Wnt-5a/Ca(2+) pathway and antagonizes canonical Wnt/beta-catenin signaling. PMID: 12482967
- characterized the molecular mechanisms of cellular stress-induced TAK1 activation, focusing mainly on the phosphorylation of TAK1 at Thr-187 and Ser-192 in the activation loop; TAB1 and TAB2 were differentially involved in the phosphorylation of TAK1 PMID: 15590691
- Determinants that control the specific interactions between TAB1 and MAPK14 are identified. PMID: 16648477
- The protein phosphatase 2C alpha fold is conserved in TAB1(a TAK1 regulatory subunit) but some AAs needed for dual metal-binding & catalysis are missing. It is a pseudophosphatase, & may bind/regulate access to phosphorylated AAs on downstream substrates. PMID: 16879102
- a TAB1:TAK1:IKK beta:NF-kappaB signaling axis forms aberrantly in breast cancer cells and, consequently, enables oncogenic signaling by TGF-beta PMID: 18316610
- TAB4 binds TAK1 and polyubiquitin chains to promote specific sites of phosphorylation in TAK1-TAB1, which activates IKK signaling to NF-kappaB. PMID: 18456659
- periostin is involved in the suppression of cell invasiveness via the TAB1/TAK1 signaling pathway. PMID: 19578758
顯示更多
收起更多
-
組織特異性:Ubiquitous.
-
數(shù)據(jù)庫鏈接:
Most popular with customers
-
YWHAB Recombinant Monoclonal Antibody
Applications: ELISA, WB, IHC, IF, FC
Species Reactivity: Human, Mouse, Rat
-
Phospho-YAP1 (S127) Recombinant Monoclonal Antibody
Applications: ELISA, WB, IHC
Species Reactivity: Human
-
-
-
-
-
-